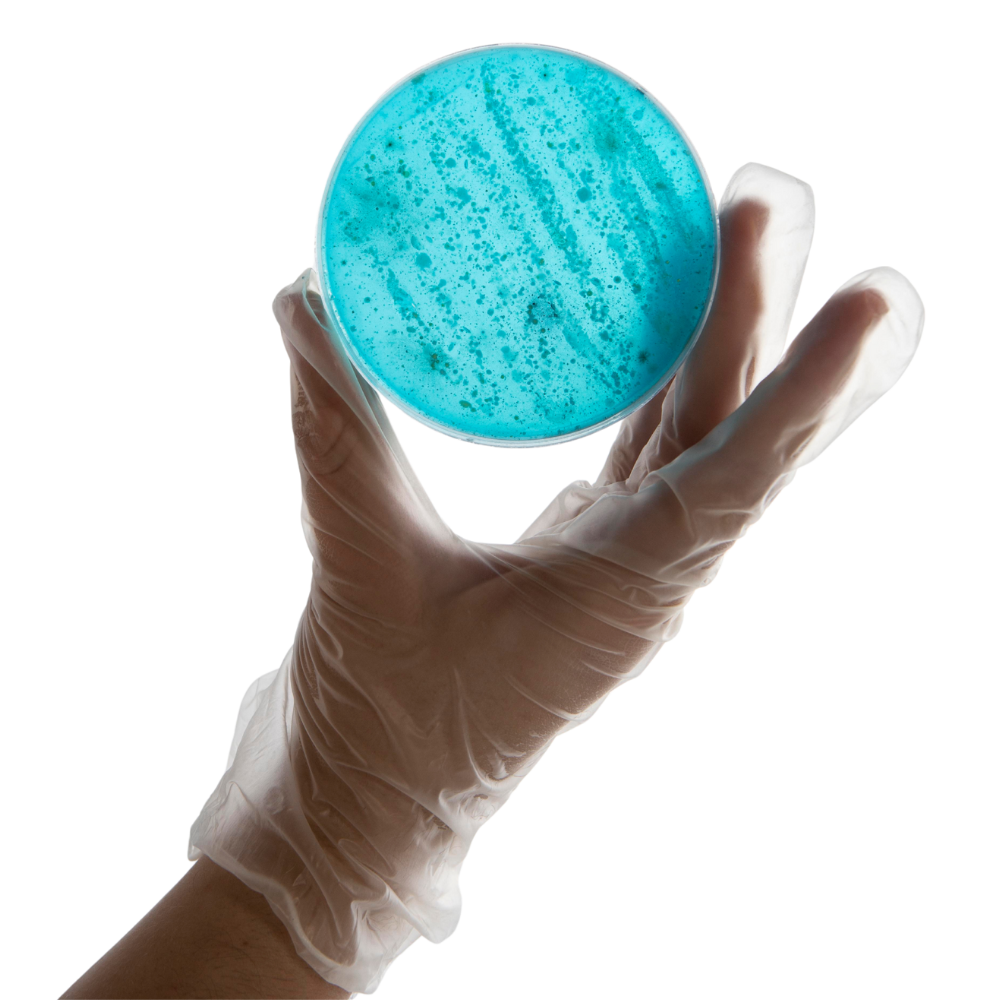
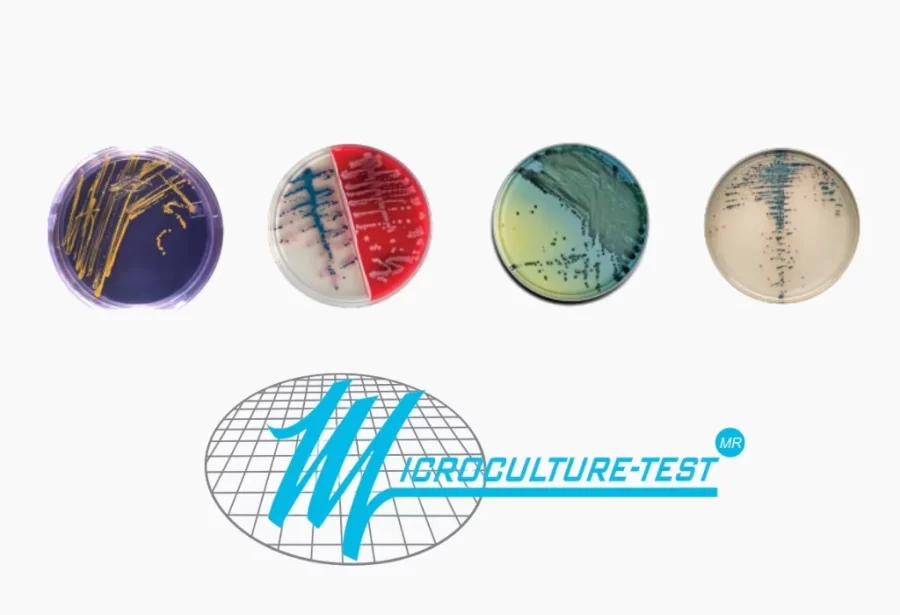

técnicas
Técnicas de análisis micriobiológico adaptadas a las necesidades de los diferentes sectores.
Desde detección de patógenos hasta pruebas rápidas o monitoreo ambiental, D Q Microbiología ofrece un abanico completo de productos para las diferentes técnicas de análisis usadas por la industria.

Filtración por membrana
Técnica de referencia para el análisis microbiológico. Permite el recuento y aislamiento de microorganismos mediante el uso de medios selectivos y membranas filtrantes.

Monitoreo ambiental
Control microbiológico del entorno en salas limpias, superficies, aire y equipos. Soluciones que incluyen medios preparados, placas de contacto y equipos activos de muestreo como los TRIO.BAS y AIRBIO.

Bionutrientes
Medios y suplementos diseñados para favorecer el crecimiento bacteriano y fúngico en distintas aplicaciones microbiológicas, esenciales en ensayos de validación y desarrollo.

Pruebas rápidas
Tecnología sencilla y rápida para obtener resultados in situ en tan solo minutos. Ideal para verificaciones de control de calidad, seguridad alimentaria o decisiones inmediatas en planta.

Antibióticos y adulteraciones
Kits de detección para residuos de antibióticos, adulteraciones alimentarias y biomarcadores de bienestar animal. Disponibles en distintos formatos para adaptar la capacidad analítica del laboratorio.

Alérgenos
Pruebas rápidas diseñadas para detectar trazas de alérgenos comunes en productos y líneas de producción. Ensayos de alta sensibilidad que ayudan a prevenir contaminaciones cruzadas.

Patógenos
Soluciones para la detección cualitativa y cuantitativa de microorganismos patógenos como Salmonella, Listeria, E. coli, entre otros. Incluye medios específicos y pruebas listas para usar.
Otros socios comerciales



























